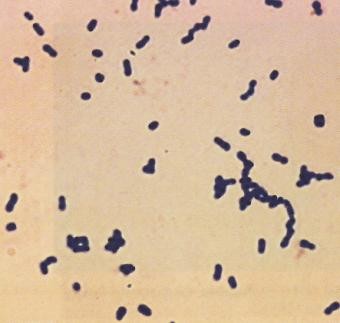
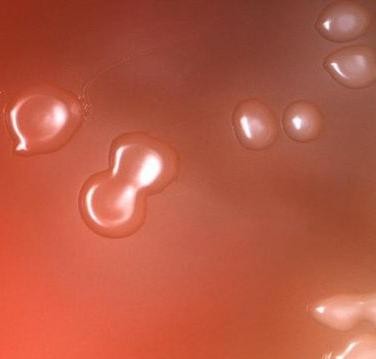
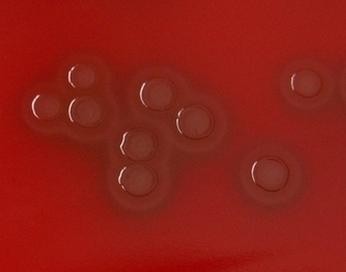

Материал: Литусов_Пиогенные кокки
Серологический метод классификации стрептококков по Р. Ленсфильд основан (один правильный ответ):
на изучении биохимической активности
на выявлении специфического группового полисахарида клеточной стенки
на определении стрептолизинов
на определении гиалуронидазы
на определении стрептокиназы.
Для S. pyogenes характерно (несколько правильных ответов):
принадлежит к группе А
облигатный анаэроб
является представителем нормальной микробиоты
возбудитель рожистого воспаления
вызывает бета-гемолиз
У стрептококков обнаруживают следующие антигены (несколько правильных ответов):
белок М
Vi-антиген
К-антиген
белок А
Н-антиген
Селективной средой для стрептококков является (один правильный ответ):
15. агар Эндо
агар Плоскирева
агар Левина
кровяной агар
висмут-сульфитный агар
Для культивирования стрептококков применяют (несколько правильных ответов):
висмут-сульфитный агар
кровяной агар
сывороточный агар
среду Эндо
среду Левина
Среда для определения гемолитических свойств стрептококков (один правильный ответ):
мясо-пептонный агар
агар с 5% крови
висмут-сульфитный агар
сывороточный агар
желточно-солевой агар
Для выделения стрептококка могут быть использованы следующие питательные среды (несколько правильных ответов):
кровяной агар
желточно-солевой агар
сывороточный агар
среда Эндо
висмут-сульфитный агар
Альфа-гемолитические стрептококки на кровяном агаре образуют (один правильный ответ):
колонии, окруженные прозрачной бесцветной зоной гемолиза
колонии, окруженные зоной гемолиза зеленого цвета
колонии темно-красного цвета с металлическим блеском
колонии без зоны гемолиза
черные колонии с бесцветной зоной гемолиза
Альфа-гемолитические стрептококки на кровяном агаре образуют (один правильный ответ):
крупные желтые колонии
мелкие колонии, окруженные зоной гемолиза зеленого цвета
мелкие колонии без зоны гемолиза
крупные колонии красного цвета
мелкие желтые колонии
Бета-гемолитические стрептококки на кровяном агаре образуют (один правильный ответ):
колонии, окруженные прозрачной бесцветной зоной гемолиза
колонии, окруженные зоной гемолиза зеленого цвета
колонии без зоны гемолиза
черные колонии с металлическим блеском
зеленые колонии
Гамма-стрептококки на кровяном агаре образуют (один правильный ответ):
колонии, окруженные прозрачной бесцветной зоной гемолиза
колонии, окруженные зоной гемолиза зеленого цвета
колонии без зоны гемолиза
колонии черного цвета
зеленые колонии
К факторам патогенности стрептококка относятся (несколько правильных ответов):
белок А
белок М
стрептолизины
дифтерийный экзотоксин
холероген
Функция М белка S. pyogenes (один правильный ответ):
гемолиз эритроцитов
инвазия в М-клетки
защита от фагоцитоза
свертывание плазмы
разрушение гиалуроновой кислоты
Бета-гемолитический стрептококк серогруппы А вызывает (несколько правильных ответов):
ангину
энтероколит
диарею
фурункулез
скарлатину
Скарлатину вызывает стрептококк, способный продуцировать (один правильный ответ):
эндотоксин
эритрогенный токсин
липополисахарид
фибринолизин
плазмокоагулазу
Определение титра антител к стрептолизину О используют для диагностики (один правильный ответ):
цистита
пиелонефрита
гепатита
ревматизма
менингита
К осложнениям стрептококковой ангины относится (один правильный ответ):
ревматизм
энтероколит
дизентерия
брюшной тиф
фурункулез
Этиологическим фактором ревматизма является (один правильный ответ):
стафилококк
бета-гемолитический стрептококк
сальмонелла
кишечная палочка
пневмококк
Для профилактики обострений ревматизма используют (один правильный ответ):
анатоксин
антитоксическую сыворотку
бактериофаг
стрептолизин
пенициллин
После перенесенной скарлатины у человека формируется (один правильный ответ):
естественный антимикробный иммунитет
искусственный антимикробный иммунитет
естественный антитоксический иммунитет
искусственный антитоксический иммунитет
пассивный антитоксический иммунитет
Streptococcus pyogenes вызывает (один правильный ответ):
брюшной тиф
энтероколит
гастроэнтерит
дизентерию
рожистое воспаление
Streptococcus pyogenes вызывает (один правильный ответ):
гастроэнтерит
энтероколит
дизентерию
ангину
брюшной тиф
Streptococcus pyogenes вызывает (один правильный ответ):
энтероколит
брюшной тиф
скарлатину
дизентерию
паратиф А
Скарлатину вызывает (один правильный ответ):
золотистый стафилококк
эпидермальный стафилококк
бета-гемолитический стрептококк
менингококк
гонококк
Возбудитель скарлатины (один правильный ответ):
Staphylococcus albus
Streptococcus faecalis
Streptococcus pyogenes
Staphylococcus epidermidis
Staphylococcus aureus
Возбудитель ангины (один правильный ответ):
сальмонелла
шигелла
кампилобактер
стрептококк
кишечная палочка
Возбудителем скарлатины является (один правильный ответ):
S. aureus
S. pyogenes
Е. faecalis
S. pneumoniae
S. salivarius
Для стрептококковых инфекций основным методом лабораторной диагностики является (один правильный ответ):
бактериоскопический
бактериологический
биологический
аллергодиагностика
серологический
Выберите изображение, соответствующее стрептококкам (окраска по Граму):
40.1 40.2 40.3 40.4 40.5
Правильные ответы: 1.5; 2.2; 3.3, 3.4; 4.5; 5.3; 6.3; 7.4; 8.4; 9.2; 10.1, 10.3; 11.2; 12.2;
13.1, 13.5; 14.1, 14.3; 15.4; 16.2, 16.3; 17.2; 18.1, 18.3; 19.2; 20.2; 21.1; 22.3; 23.2, 23.3;
24.3; 25.1, 25.5; 26.2; 27.4; 28.1; 29.2; 30.5; 31.3; 32.5; 33.4; 34.3; 35.3; 36.3; 37.4; 38.2;
39.2; 40.4.
Пневмококки
Особое положение среди представителей рода Streptococcus занимает вид S. рneumoniae (пневмококк). Этот микроб впервые обнаружил в плевральной жидкости у пациентов с пневмонией в 1875 г. немецкий бактериолог Э. Клебс (рисунок 1.70).

Рисунок 1.70 – Эдвин Клебс (Edwin Klebs, 1834 – 1913 гг.). Заимствовано из Интернет-ресурсов.
В 1881 г. Л. Пастер и Дж. Стернберг независимо друг от друга описали фатальную септицемию у кроликов, вызванную подобным стрептококком.
В 1886 г. немецкий врач А. Френкель при крупозной пневмонии обнаружил расположенные попарно коки и назвал их Diplococcus pneumoniae. Подобные диплококки описал А. Вексельбаум (рисунок 1.71). В связи с этим диплококки часто называют диплококком Френкеля или диплококком Вексельбаума.


А Б
Рисунок 1.71 – А - Альберт Френкель (Albert Fraenkel, 1848 – 1916 гг.), Б - Антон Вексельбаум (Anton Weichselbaum, 1845-1920 гг.). Заимствовано из Интернет-
ресурсов.
В начале ХХ века немецкий бактериолог Ф. Нейфельд (рисунок 1.72) впервые с помощью типоспецифических антисывороток разделил пневмококки на серотипы.

Рисунок 1.72 – Фред Нейфельд (Fred Neufeld, 1869-1945 гг.). Заимствовано из Интернет-ресурсов.
Для серотипирования пневмококков Ф. Нейфельд использовал метод набухания капсулы (рисунок 1.73).
 Обычная
капсула
Обычная
капсула
Набухшая капсула
Рисунок 1.73 – Набухание капсулы пневмококка при добавлении сыворотки, содержащей антитела против капсульных полисахаридов данного серотипа.
Заимствовано из Интернет-ресурсов.
В 1974 г. этот микроорганизм получил современное название Streptococcus pneumoniae.
 Морфологические
и тинкториальные свойства пневмококков.
Пневмококки
представляют собой грамположительные
бактерии ланцетовидной формы размером
0,8-1,25 мкм, располагающиеся попарно. Такое
расположение клеток обусловлено их
делением в одной плоскости (рисунок
1.74).
Морфологические
и тинкториальные свойства пневмококков.
Пневмококки
представляют собой грамположительные
бактерии ланцетовидной формы размером
0,8-1,25 мкм, располагающиеся попарно. Такое
расположение клеток обусловлено их
делением в одной плоскости (рисунок
1.74).
![]()

Рисунок 1.74 – Расположение клеток при делении пневмококков.
Каждая пара кокков окружена капсулой полисахаридной природы.
Пневмококки имеют пили, они неподвижны, не образуют спор (рисунок 1.75).

а б в
Рисунок 1.75 – Схематическое изображение (а), окраска по Граму (б) и электронная фотография пневмококка (в). Заимствовано из Интернет-ресурсов.
Геном пневмококка представляет собой кольцевую хромосому. В природе пневмококк подвержен генетической изменчивости путем трансформации, поэтому в его геноме обнаруживаются чужеродные гены. Именно на примере пневмококков в 1928 году британским ученым Ф. Гриффитом был описан феномен генетической трансформации.
Культуральные и биохимические свойства пневмококков. Пневмококки являются факультативными анаэробами. Их рост усиливается в атмосфере 5-10% углекислого газа. На агаре пневмококки формируют мелкие выпуклые колонии влажной консистенции. При инкубировании более 48 часов центральная часть колоний опускается, образуя характерную блюдцеобразную форму (рисунок 1.76).
Рисунок 1.76 – Блюдцеобразная форма колоний пневмококков. Заимствовано из Интернет-ресурсов.
Оптимальная температура роста для пневмококков 37°С. Они требовательны к питательным средам, для их выращивания используют сывороточный или кровяной агар с добавлением глюкозы. На средах с кровью пневмококки вызывают α-гемолиз - формируют мелкие колонии, окруженные зоной зеленого цвета за счет неполного гемолиза и образования метгемоглобина (рисунок 1.77).
Рисунок 1.77 – Характер роста пневмококков на кровяном агаре. Заимствовано из Интернет-ресурсов.
В жидких средах пневмококки вызывают диффузное помутнение и небольшой хлопьевидный осадок. Они ферментируют некоторые углеводы (левулезу, маннозу, глюкозу, галактозу, лактозу, мальтозу, сахарозу). Пневмококк является каталазоотрицательным и оксидазоотрицательным микроорганизмом. Важным отличительным признаком пневмококков является ферментация инулина, позволяющая отличить его от зеленящего стрептококка, не обладающего способностью разлагать инулин. Пневмококк свертывает молоко, желатин не разжижает.
Антигенная структура пневмококка сложная. В клетке локализуется антиген белковой природы, обладающий типовой специфичностью. В клеточной стенке имеется несколько антигенов. Капсульные полисахаридные К-антигены состоят из повторяющихся сочетаний моносахаридов (D-глюкозы, D-галактозы и L- рамнозы). В зависимости от химического строения капсулы выделяют более 90 серотипов пневмококков. В настоящее время используются 2 номенклатурные схемы: американская и датская. В соответствии с американской схемой серотипы пневмококков имеют нумерацию в порядке их описания, без учета перекрестного реагирования. Согласно датской (международной) схеме, серотипы пневмококков объединены в 47 групп с учетом антигенного родства. Серогруппы обозначают арабскими цифрами, а серотипы – заглавными латинскими буквами. Чаще всего заболевание вызывают около 20 серотипов пневмококков, на основе которых конструируют пневмококковые вакцины. В России наиболее часто колонизируют носоглотку штаммы пневмококков серотипов 19F, 6В, 14.
Другой антиген клеточной стенки представляет собой тейхоевую кислоту. М-белок пневмококков также представляет собой антиген клеточной стенки и аналогичен М-белку других видов стрептококков.
Факторы патогенности пневмококков. Среди факторов патогенности пневмококков выделяют структурные компоненты клетки, выполняющие в основном функцию адгезии, и секретируемые субстанции (ферменты агрессии и токсины). Основные факторы патогенности пневмококков представлены в таблице
1.5 и на рисунке 1.78.
Таблица 1.5 – Факторы патогенности пневмококков
Название фактора |
Выполняемая функция |
1. Структурные компоненты клетки |
|
1.1 Капсула |
Препятствие фагоцитозу |
1.2. Структуры и белки системы MSCRAMM |
|
Пили |
Адгезия |
Концевой пилиновый белок RrgA |
Адгезия |
М-белок |
Фактор адгезии и защиты от фагоцитоза |
Тейхоевая кислота |
Связывание с эпителием носоглотки |
Холин-связывающие белки PspА, PspС |
Участвуют в адгезии и колонизации |
Фибронектин-связывающий белок (Fbp) |
Адгезия |
2. Секретируемые компоненты |
|
2.1. Ферменты агрессии |
|
Нейраминидаза |
Расщепляет нейраминовую кислоту |
Гиалуронидаза |
Расщепляет гиалурон-содержащие компоненты внеклеточного матрикса |
Энолаза |
Связывается с плазминогеном |
Аутолизин А (LytA) |
Расщепляет клеточную стенку, способствуя освобождению пневмолизина |
IgA-протеаза |
Расщепляет IgA человека |
Lux-контролируемая система quorum sensing |
Образование биопленки |
Бактериоцин (пневмоцин) |
Подавление других представителей экологической ниши |
2.2. Токсины |
|
Пневмолизины (Ply) - α и β - цитотоксины |
Порообразующие токсины |
Лейкоцидин |
Разрушение лейкоцитов |